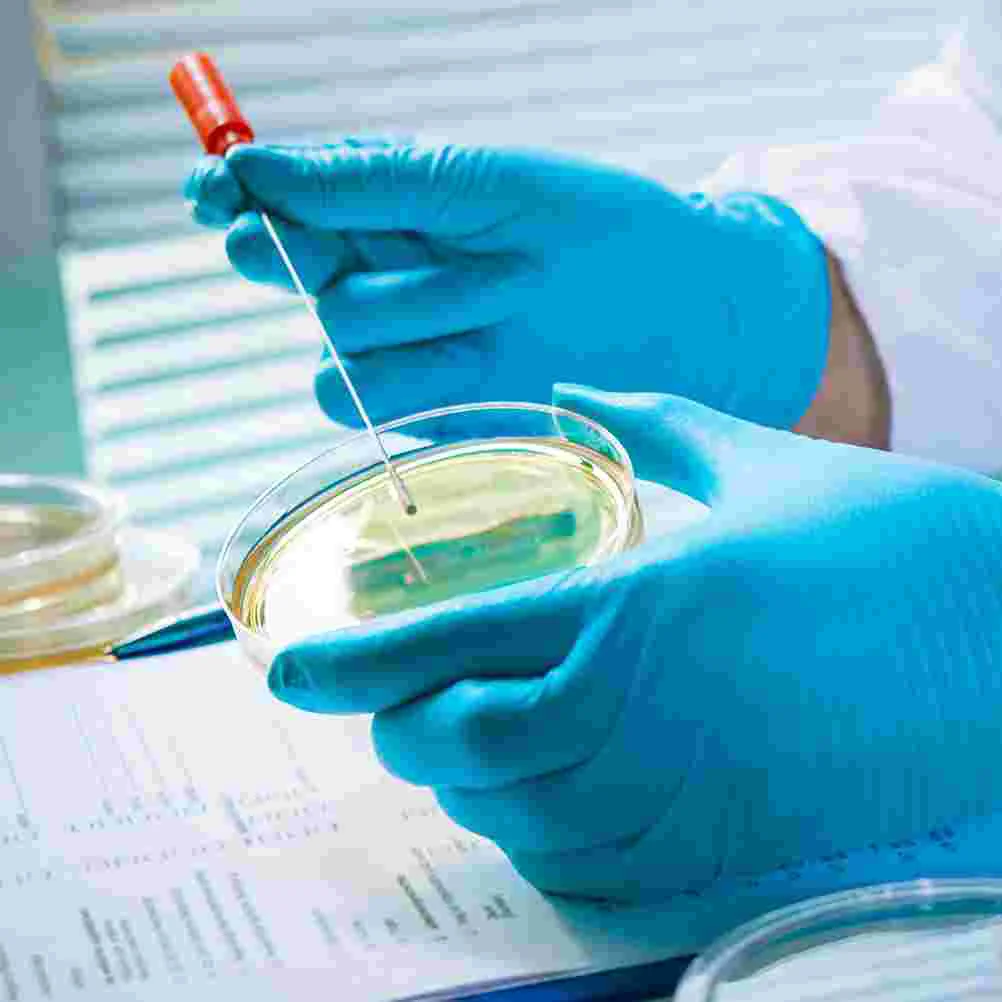

MamaSuka - Agar-agar Hallow 7 gr
Description
Tepung agar-agar Hallow merupakan tepung agar-agar yang sudah ditambah dengan vanila dan pewarna makanan yang diizinkan, sebagai bahan untuk membuat aneka makanan yang berbasis agar-agar, puding, dan sebagainya. Agar-agar ini memiliki 4 varian, yakni Plain (putih), Merah, Coklat, dan Hijau dengan berat masing-masing 7 gr.
Cara melakukan komplain produk:
1. Mohon melakukan Video Unboxing (Pembukaan Paket), Foto Penerimaan Produk, Foto Resi dan Label Pembeli saat paket sudah berhasil diterima sehingga jika ada Kerusakan, Kekurangan Produk/Hadiah, atau Ketidaksesuaian Produk yang diterima bisa dilakukan validasi melalui kelengkapan tersebut.
2. Jika tidak ada atau hanya memiliki salah satu dari kelengkapan yang disebutkan, maka segala bentuk komplain yang masuk tidak bisa ditindak lanjuti atau dianggap tidak sah. *Kecuali memang ada kesalahan dari sisi Penjual.
3. Apabila kerusakan packaging hanya pada bagian luar (bagian dalam utuh, produk tidak ada kerusakan/kekurangan, dll), maka kerusakan disebabkan penanganan paket dari Pihak Jasa Ekspedisi yang kurang baik. Diharapkan agar Pembeli bisa melakukan komplain langsung ke Pihak Jasa Ekspedisi.
Untuk info lebih lanjut, silahkan hubungi CS kami.
Cara melakukan komplain produk:
1. Mohon melakukan Video Unboxing (Pembukaan Paket), Foto Penerimaan Produk, Foto Resi dan Label Pembeli saat paket sudah berhasil diterima sehingga jika ada Kerusakan, Kekurangan Produk/Hadiah, atau Ketidaksesuaian Produk yang diterima bisa dilakukan validasi melalui kelengkapan tersebut.
2. Jika tidak ada atau hanya memiliki salah satu dari kelengkapan yang disebutkan, maka segala bentuk komplain yang masuk tidak bisa ditindak lanjuti atau dianggap tidak sah. *Kecuali memang ada kesalahan dari sisi Penjual.
3. Apabila kerusakan packaging hanya pada bagian luar (bagian dalam utuh, produk tidak ada kerusakan/kekurangan, dll), maka kerusakan disebabkan penanganan paket dari Pihak Jasa Ekspedisi yang kurang baik. Diharapkan agar Pembeli bisa melakukan komplain langsung ke Pihak Jasa Ekspedisi.
Untuk info lebih lanjut, silahkan hubungi CS kami.
Price history chart & currency exchange rate
Customers also viewed

22%
$0.37
Canvas Painting Nordic What Mama Needs Poster Autumn Must Haves Nursery Art Print Modern Wall Picture For Living Room Home Decor
aliexpress.com
8%
$0.61
10pcs 30mm Transparent Color Hallow Star Acrylic Beads Earring Charms Flower Spacer Necklace Accssories DIY Jewelry Departments
aliexpress.com
-1%
6%
$0.51
Mama Design 3D UV DTF Wraps Stickers Cute Wraps For 16 OZ Glass Libbey Selfadhesive Washable DIY Custom Cups Wrap Stickers
aliexpress.com
5%
$0.30
Discover the Versatility of the Stainless Steel Wire Brush Set, 3Pcs Set for All Your Cleaning and Polishing Needs
aliexpress.com
3%
$0.57
Secure Mounting Portable Speaker Handle Audio Speaker Handle Daily Needs Great Workmanship Secure Mounting Simple Design
aliexpress.com
1%
$0.62
Mini Solar Calculator with 8 Digit Display for Students, Teachers, and Budgeting Needs Easy Portability DropShipping
aliexpress.com
1%
$0.53
Q2Q4 Stainless Steel Feeler Gauges Double Marked for Accurate Measurements Various Measuring Needs Engineering Vehicle Repair
aliexpress.com
1%
$0.57
Newest Design Valentine's Day Party Supplies Personalized Hallow-out Carved Heart Wooden Ornament
dhgate.com
1%
$0.39
Y1UB Flexible RJ9 RJ11 4P4C Handsets Cord 200cm 300cm Telephone Line For Office Staff And Home Communication Needs
aliexpress.com
1%
$0.23
Q2Q4 Heavy Duty Multifunction Steel Wrench Spanner Suitable For Various Repair Needs Automotive Maintenance Professional Use
aliexpress.com
1%
$0.28
Keychain Practical and Trendy Zinc Alloy Keychain with 8 Shape Buckle and Horseshoe Buckle for All Your Key Needs
aliexpress.com
1%
$0.65
Love Mom Gift Mama Necklace Silver Plated Jewelry Gift For Mother MUM Letters Heart Pendant Necklace Wholesale
alibaba.com
1%
$0.22
652F Fast Speed Type C to Type C Charging Cable 120W for Rapid Data Transfer and Quick Charging Needs
aliexpress.com
1%
$0.53
10 Pcs Culture Plate Petri Dishes Plastic Science Experiment Supplies with Lids for Agar Plates Tissue Plant
aliexpress.com
1%
$0.14
Socket Adapter The Perfect Solution to Your Drilling Needs 1/4 Drill Socket Adapter for Impact Driver Hex Shank
aliexpress.com
-2%
1%
$0.28
Keychain Sturdy and Fashionable Zinc Alloy Keychain with 8 Shape Buckle and Horseshoe Buckle for All Your Needs
aliexpress.com
1%
$0.50
Polished And Chrome Plated Mm Screwdriver Bits Comfortable Grip Mm Adapter Screwdriver Handle Meet Different Work Needs
aliexpress.com
1%
$0.23
652F Fast Speed Type C to Type C Charging Cable 120W for Rapid Data Transfer and Quick Charging Needs
aliexpress.com
1%
$0.43
652F Delay Switches Voice Controlled Light Stand E27 Lamp Base for 110-220V Lighting Fixture Meet Various Lighting Needs
aliexpress.com
+2%
1%
$0.66
Metric Miter Track Measuring Tape Scale Ruler Steel Construction Perfect for Any Woodworking Project or Workshop Needs
aliexpress.com
1%
$0.44
T3LB Durable and Reliable DCs Charging Connector DCs Plug Connector Tips Perfect for All Your Power Needs 5521 to X205T,
aliexpress.com
1%
$0.28
Gear Shift Knob Thread Adapter Nut Set 5PCs of M10x15/M10x125/M8x125 Inserts to Fit Your Car’s Needs Made of Aluminum Alloy
aliexpress.com
1%
$0.57
85WD Professional Practical DIY Instrument Housing Enclosure Box for Electronics Wiring Needs with Waterproof Feature
aliexpress.com
1%
$0.78
Full Square/Round Drill 5D DIY Diamond Painting "Cartoon doll" Embroidery Cross Stitch 3D Home Decor
aliexpress.com
1%
$13.48
Топливный инжектор HaiGeXing 0928400670, измерительный клапан, регулятор давления для грузовиков VOLVO FE PENTA RENAULT DEUTZ
aliexpress.ru